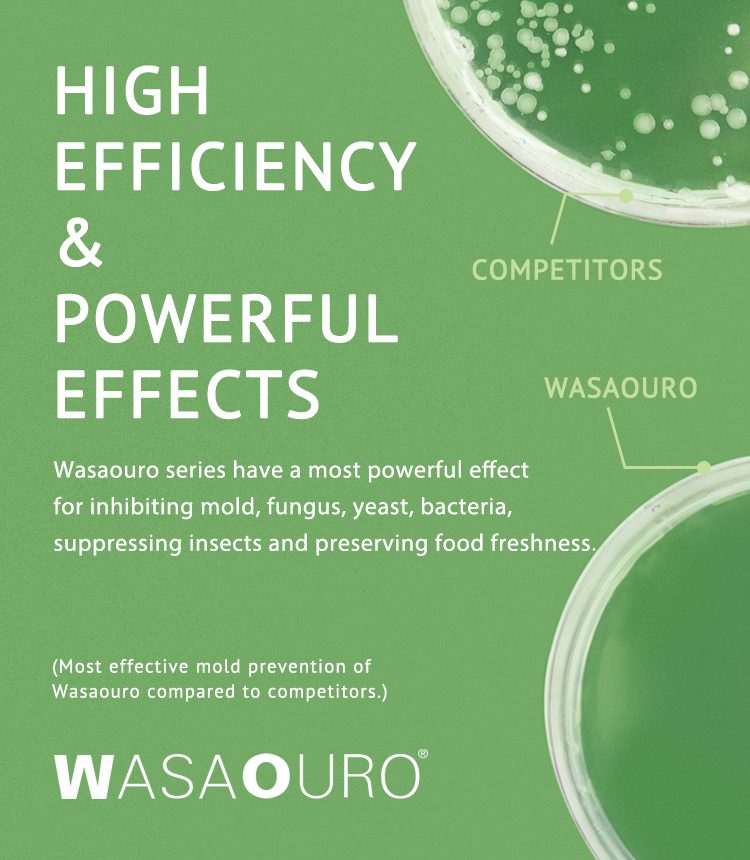

Mold prevention experience
Competitive Pricing
Friendly Environment
Mold Knowledge Training

Fungus spores are everywhere in the air. Regardless how high the temperature and humidity, mold growth can be prevented by killing or inhibiting fungus spores on the merchandise. Based on this theory and concept, Kenbo provides a series of Wasaouro anti-mold products.
These products offer a wide range of applications suitable for shoes, apparel, bags, leather goods, etcetera. They are environmentally friendly and highly efficient. Kenbo offers their customers best service, high technology and competitive prices in order to meet the customer's mold prevention plan in the market.
Our Product Family
Kenbo is in the business of mold prevention. We focus on the combination of developing the most effective products for mold prevention and applications which are designed to prevent mold growth by eliminating or killing any residual fungus spores. Our products are very easy to use with no toxic substances and are able to comply with safety and environmental standards set by individual companies policies.
Wasapaper 3
Wasapaper 3 is a safe, env […]Wasaouro YL (Sticker Type)
Wasaouro YL stickers are a […]Wasaouro FS (Non Sticker Type)
Wasaouro FS is a safe, eas […]Wasaouro Liquid
Wasaouro liquid is […]